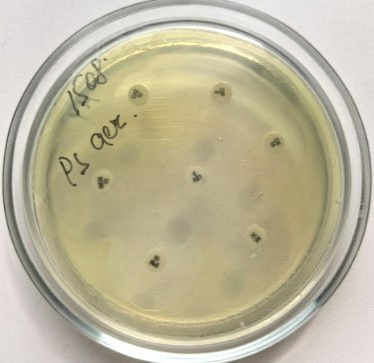
Нижегородка подхватила жуткую инфекцию из-за маникюра - фото 1

Нижегородка подхватила синегнойную палочку из-за маникюра гель-лаком. Об этом рассказал редактор «Стационар-пресс» Алексей Никонов в своем Telegram-канале.
Девушка заразилась Pseudomonas aeruginosa из-за того, что ноготь повредился нагреванием и под слоем покрытия образовалась благоприятная среда для развития инфекции. Теперь ей прописали антибиотики.

При этом, по словам врача-дерматовенеролога Нижегородского филиала Государственного научного центра дерматовенерологии и косметологии Ильи Макарычева, заразиться можно и дома: например, бактерия может обитать на губках для мытья посуды, на сантехники, раковинах и в стоячей воде.
Чем больше контактов — тем выше риск заразиться, — объяснил врач.
На ногтях пальцев ног синегнойная палочка может появиться из-за тесной обуви.
Ранее сообщалось, что нижегородские врачи спасли молодую женщину с тромбоэмболией.
Самые интересные и срочные новости читайте в «В городе N»


